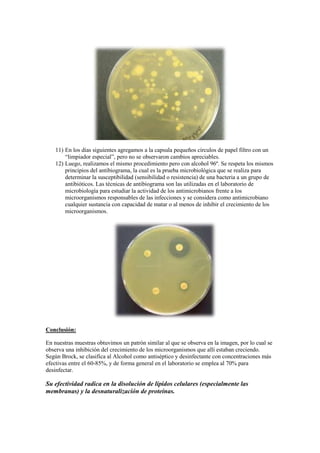
11) En los días siguientes agregamos a la capsula pequeños círculos de papel filtro con un
        “limpiador especial”, pero no se observaron cambios apreciables.
    12) Luego, realizamos el mismo procedimiento pero con alcohol 96º. Se respeta los mismos
        principios del antibiograma, la cual es la prueba microbiológica que se realiza para
        determinar la susceptibilidad (sensibilidad o resistencia) de una bacteria a un grupo de
        antibióticos. Las técnicas de antibiograma son las utilizadas en el laboratorio de
        microbiología para estudiar la actividad de los antimicrobianos frente a los
        microorganismos responsables de las infecciones y se considera como antimicrobiano
        cualquier sustancia con capacidad de matar o al menos de inhibir el crecimiento de los
        microorganismos.




Conclusión:

En nuestras muestras obtuvimos un patrón similar al que se observa en la imagen, por lo cual se
observa una inhibición del crecimiento de los microorganismos que allí estaban creciendo.
Según Brock, se clasifica al Alcohol como antiséptico y desinfectante con concentraciones más
efectivas entre el 60-85%, y de forma general en el laboratorio se emplea al 70% para
desinfectar.

Su efectividad radica en la disolución de lípidos celulares (especialmente las
membranas) y la desnaturalización de proteínas.

El documento describe diferentes tipos de medios de cultivo utilizados para el cultivo de microorganismos en el laboratorio. Explica que un medio de cultivo proporciona nutrientes para el crecimiento de microorganismos. Luego clasifica los medios de cultivo en naturales, sintéticos, semisintéticos, líquidos, sólidos y semisólidos según su origen y consistencia. También los clasifica en comunes, enriquecidos, selectivos y diferenciales según su composición y propósito. Finalmente, detalla los pasos